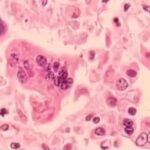
Second measles case of 2026 confirmed in Georgia

Chilling Surrogacy Abuse: 14-Year-Old Pregnant
A 14-year-old Oklahoma girl is pregnant with twins after her own mother and the mother's boyfriend allegedly used the child as a surrogate, according...
Red State Boom: Families Flee High-Cost Blue States
Red states under President Trump's leadership are booming with young families fleeing unaffordable blue-state policies, proving conservative values foster family growth and national renewal.Story...
Media Bias Exposed: Reporter Ignores Directives
A viral moment at the Texas Capitol exposed how quickly legacy media can try to steer cameras away from pro-Trump reality.Story SnapshotCBS Austin reporter...
Duke Rape Liar Walks Free
Crystal Mangum confessed 18 years later that she fabricated the Duke lacrosse rape story, but her recent prison release adds a shocking new twist...
Fixed Rates Drop—Is This a Game Changer?
Canadian homebuyers finally breathe easier as mortgage rates dip below 6% for the first time in nearly four years, but will this relief last...
Trump Orders Embassy Evacuation—War Imminent?
U.S. State Department orders non-emergency embassy staff in Israel to evacuate immediately, signaling imminent war risks from Iranian missile threats despite ongoing nuclear talks.Story...
Late-Night Suicide Searches Trigger Parent Alert
Instagram is about to turn a teen’s repeated late-night “how do I…” searches into a message that lands on a parent’s phone.Quick TakeMeta says...
Omar & Tlaib’s Outrageous State of the Union Outburst
Squad members Ilhan Omar and Rashida Tlaib turned President Trump's State of the Union address into a chaotic spectacle of outbursts and disruptions that...
Shocking Measles Outbreak: No End in Sight!
Measles deaths in today’s America aren’t a mystery outbreak—they’re a math problem we’ve chosen not to solve.Quick TakeMeasles surged to 2,281 confirmed U.S. cases...
Abuse Legalized—Taliban Permits Wife Beatings
Husbands in Taliban-controlled Afghanistan can now legally beat their wives and children without broken bones or open wounds, turning family homes into sanctioned battlegrounds.Story...